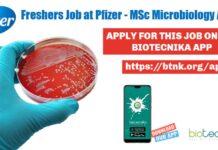
Freshers Job at Pfizer, Senior Executive Microbiology – Apply Online Freshers Job at Pfizer

CSIR-IGIB COVID19 Project Recruitment, Applications Invited Online
CSIR-IGIB Research Project Recruitment, Applications Invited Online
CSIR-IGIB Research Project Recruitment, Applications Invited Online. MSc/MTech/ Doctoral candidates are eligible to apply. Project Associate Job Openings....
Know Your Biotech Company – KYC Series Starts 17th Sept 2021 – Check Details
Know Your Biotech Company Series Starts 17th Sept 2021
👉 Download the Biotecnika App Now 👈
After Installing: Goto Webinar Section >> Upcoming to see Schedule
In...
Freshers Job at Pfizer, Senior Executive Microbiology – Apply Online
Freshers Job at Pfizer, Senior Executive Microbiology - Apply Online
Freshers Job at Pfizer, Senior Executive Microbiology - Apply Online. Pfizer is hiring candidates for...
FREE CSIR NET Crash Course Schedule – Exclusively on Biotecnika App
FREE CSIR NET Crash Course Schedule - Exclusively on Biotecnika App
Dear Biotecnikans,
Please find the schedule of the classes for the FREE CSIR NET Crash...
ICGEB Plant RNAi Biology Group Life & Biological Sciences Recruitment
ICGEB Biological Sciences SRF - Life Sciences Vacancy
ICGEB Biological Sciences SRF - Life Sciences Vacancy. MSc Biological & Life Sciences candidates are encouraged to...
SARS-COV2 Anti-Viral Activity Project Recruitment at THSTI, Apply Online
THSTI Project Job Openings With Rs. 54,000 pm Salary
THSTI Project Job Openings With Rs. 54,000 pm Salary. MSc & PhD check out the details...
Govt National Tuberculosis Institute Recruitment, Applications Invited
National Tuberculosis Institute Recruitment, Applications Invited
National Tuberculosis Institute Recruitment, Applications Invited. National Tuberculosis Institute (NTI), a Government of India Organization under the Ministry of...
Panjab University Project Assistant Vacancy Available, Applications Invited
Panjab University Project Assistant Vacancy Available, Applications Invited
Panjab University Project Assistant Vacancy Available, Applications Invited. Candidates with MSc Microbiology/ Biotechnology/ Biochemistry/Lifesciences qualifications can apply for...
AIIMS Delhi Research Associate Job For Biotech, Biochem & Life Sciences
AIIMS Delhi Post - PhD Biotech, Biochem & Life Sciences Apply
AIIMS Delhi Post - PhD Biotech, Biochem & Life Sciences Apply. Research Associate job...
Syneos Life Sciences Senior Associate Recruitment, Apply Online
Syneos Life Sciences Associate Recruitment, Apply Online
Syneos Life Sciences Associate Recruitment, Apply Online. MSc Life Sciences candidates with relevant experience to fill the vacancy...
SARS-COV-2 Project Recruitment With Rs. 45,000 pm Pay at IISER Pune
IISER Pune Research Associate Job - Biological Sciences Apply
IISER Pune Research Associate Job - Biological Sciences Apply. IISER Pune is hiring Biological Sciences Position....
GAT-B/BET 2021 Results Declared – Qualified Candidates List & Marks
GAT-B/BET 2021 Results Declared - Qualified Candidates List & Marks
GAT-B/BET 2021 Results Declared - Qualified Candidates List & Marks. The results for the recently...
FREE Molecular Docking Internship Starts 15th Sept 2021 – Check Details & Schedule
FREE Molecular Docking Internship Starts 15th Sept 2021
👉 Download the Biotecnika App Now 👈
After Installing: Classes >> Upcoming to see Schedule
Tune in to the...
🎁 FREE – CSIR NET Crash Course Starts Today IN Biotecnika App – Check...
CSIR NET FREE Crash Course Starting Today
👉 Download the Biotecnika App Now 👈
No Registration Needed
Tune in @ 7 PM Today to Attend 1st Live...
RGCB MSc Biotechnology Admission 2021-2023, Apply Online
RGCB MSc Biotechnology Admission 2021-2023, Apply Online
The notification for the RGCB MSc Biotechnology Admission 2021-2023, Apply Online Session has now been released. Applicants who...